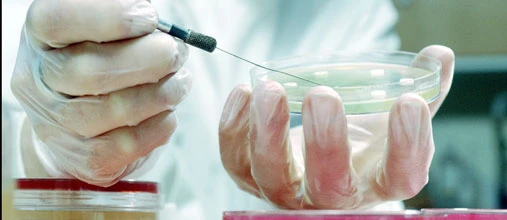
Anlage-Profis: Morphosys lockt sogar US-Investoren

Die Euro am Sonntag Morphosys freuen sich für Morphosys. Mit Johnson & Johnson hat erstmals ein Partner die Zulassung für ein von Morphosys entwickeltes Medikament beantragt. Guselkumab soll dabei gegen Schuppenflechte eingesetzt werden. Andererseits verkaufte Morphosys jedoch 2,62 Millionen neue Aktien zu je 44 Euro an institutionelle Investoren und verprellte wegen der daraus resultierenden Verwässerung die Anleger, der Aktienkurs sank. Mit den 115 Millionen Euro brutto aus dieser Kapitalerhöhung soll die Forschung finanziert werden. Grundsätzlich stimmt es jedoch bei dem Biotechnologie-Unternehmen: Neben der möglichen ersten Medikamenten-Zulassung und dem nun ausreichend hohen Finanzpolster von 300 Millionen Euro stimmt auch die Tatsache zuversichtlich, dass die Hälfte der neuen Aktien von US-Investoren gekauft worden sind. Entsprechend sollten Anleger die mit einem KBV von 3,5 bewertete Aktie mit einem Kursziel von 53 Euro und einer Absicherung bei 36,50 Euro kaufen.
Regel Nr.1: Verliere kein Geld!

Weitere Informationen und Bestellmöglichkeiten finden Sie hier
Bevor Phil Town zu "Phil Town, der pro Jahr mehr als 500.000 Menschen Investmentregeln beibringt" wurde, war er wie alle anderen. Er hielt Geldanlage für zu kompliziert, um darin erfolgreich sein zu können. Als ehemaliger Angehöriger der Eliteeinheit Green Berets, der seinen Lebensunterhalt als River Guide verdiente, schien ihm der ganze Prozess zu undurchsichtig.Um es richtig zu machen - davon war er überzeugt - müsse man es als Vollzeitjob betreiben. Das war nicht sein Ding. Dann allerdings lernte er die Regel Nummer 1 kennen. Sie ist ganz einfach: "Verliere kein Geld!"In seinem Buch erklärt Town, wie er mithilfe dieser einen Regel in fünf Jahren aus 1.000 Dollar eine Million machte. Er zeigt, dass "kein Geld verlieren" an der Börse gleichbedeutend ist mit "mehr Geld verdienen, als man sich je vorgestellt hätte". Town redet Klartext: "Ich werde Ihre Zeit nicht mit Gelaber verschwenden, nicht mit klugen Geschichten, die Ihnen Sachen sagen, die Sie bereits wissen. Der Deal ist einfach: Ich bringe Sie ans Ziel, und zwar Schritt für Schritt."

 DER AKTIONÄR – Unsere App
DER AKTIONÄR – Unsere App

Sofortkauf
Sofortkauf